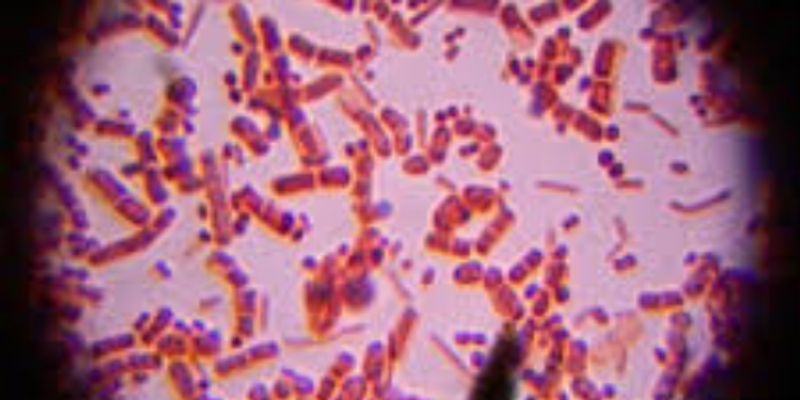

Microbials
Microbials (Bacteria) are unique living organisms that live their life as a single cell for its entirety. Bacillus is a specific type of (genus) of bacteria which grow aerobically (with oxygen) and to some extent anaerobically (without oxygen and forms spores. Microbial pre-treatment, also known as pre-acidification or multi-stage fermentation, is a simple kind of pre-treatment technology in which the first steps of anaerobic digestion (hydrolysis and acidogenesis) are separated from acetogenesis and methanogenesis.
What's Popular in Microbials
-
JUN 12, 2024MicrobiologyIn the late 1970s, a new branch was added to the tree of life, and archaea joined bacteria and eukarya, as domain classi ...Written By: Carmen LeitchMAR 05, 2024Cell & Molecular BiologyThe microbes in our gastrointestinal tract can influence our health in many ways. Researchers are starting to learn more ...Written By: Carmen LeitchFEB 26, 2024MicrobiologySome soils in Iceland like those in this image are heated naturally, giving scientists like Dr Christina Kaiser a chance ...Written By: Carmen LeitchFEB 16, 2024MicrobiologyOrganic life on earth dies, and when that happens, it must decompose. Most decomposing organic material on Earth is dead ...Written By: Carmen LeitchFEB 14, 2024Earth & The EnvironmentHow can coral bleaching impact aquatic life, overall? This is what a recent study published in Communications Biology ho ...Written By: Laurence Tognetti, MSc
JUN 12, 2024
Microbiology
In the late 1970s, a new branch was added to the tree of life, and archaea joined bacteria and eukarya, as domain classi
...
Written By:
Carmen Leitch
MAR 05, 2024
Cell & Molecular Biology
The microbes in our gastrointestinal tract can influence our health in many ways. Researchers are starting to learn more
...
Written By:
Carmen Leitch
FEB 26, 2024
Microbiology
Some soils in Iceland like those in this image are heated naturally, giving scientists like Dr Christina Kaiser a chance
...
Written By:
Carmen Leitch
FEB 16, 2024
Microbiology
Organic life on earth dies, and when that happens, it must decompose. Most decomposing organic material on Earth is dead
...
Written By:
Carmen Leitch
FEB 14, 2024
Earth & The Environment
How can coral bleaching impact aquatic life, overall? This is what a recent study published in Communications Biology ho
...
Written By:
Laurence Tognetti, MSc
FEB 08, 2024
Cell & Molecular Biology
For many years, rates of sexually transmitted infections (STIs) were getting lower, but that trend has reversed in recen
...
Written By:
Carmen Leitch
FEB 06, 2024
Microbiology
Preservatives can be important additions to food products, because they help reduce the likelihood of food borne illness
...
Written By:
Carmen Leitch
JAN 30, 2024
Cell & Molecular Biology
Viruses are entities that have to infect other cells in order to replicate. They may have genomes that are made of DNA o
...
Written By:
Carmen Leitch
JAN 29, 2024
Microbiology
Our immune systems can often eliminate bacterial infections, but sometimes those bacteria are very tough and persistent,
...
Written By:
Carmen Leitch
-
MAR 28, 2024 | 8:00 AMFlow cytometry is a powerful method for the quantification of microorganisms, unparalleled by other technologies. We will (1) give an overview of the benefits and use cases of flow cytometry...MAR 27, 2024 | 8:00 AMMetabolomics research involves two approaches: untargeted analysis, which provides a broad overview of molecular changes but lacks precision, and targeted analysis, which focuses on specific...NOVEMBER 16, 2023 2:00 PM ETDuring this presentation we will look at the methods for performing microbial testing of liquids. We will review the equipment and discuss some......Speaker: Michel van MusschenbroekOCT 12, 2023 | 6:00 AMAcute coughing is one of the most common reasons for consulting in primary care thus driving considerable antibiotic use and health-care costs. Currently, identification of microbial etiolog...Speaker: Prof. Dr. Greet Ieven, PhD , Israel Figueroa , Jelena Feenstra, PhDSponsored By: Thermo Fisher ScientificSEP 14, 2023 | 10:00 AMIn this webinar, Victoria Quiett of Thermo Fisher Scientific will dive into a comprehensive look at key components of running Pharmacogenomics (PGx) in your lab. The webinar will discuss the...
MAR 28, 2024 | 8:00 AM
Flow cytometry is a powerful method for the quantification of microorganisms, unparalleled by other technologies. We will (1) give an overview of the benefits and use cases of flow cytometry...
MAR 27, 2024 | 8:00 AM
Metabolomics research involves two approaches: untargeted analysis, which provides a broad overview of molecular changes but lacks precision, and targeted analysis, which focuses on specific...
NOVEMBER 16, 2023 2:00 PM ET
During this presentation we will look at the methods for performing microbial testing of liquids. We will review the equipment and discuss some......
Speaker:
Michel van Musschenbroek
OCT 12, 2023 | 6:00 AM
Acute coughing is one of the most common reasons for consulting in primary care thus driving considerable antibiotic use and health-care costs. Currently, identification of microbial etiolog...
Speaker:
Prof. Dr. Greet Ieven, PhD
, Israel Figueroa
, Jelena Feenstra, PhD
Sponsored By: Thermo Fisher Scientific
SEP 14, 2023 | 10:00 AM
In this webinar, Victoria Quiett of Thermo Fisher Scientific will dive into a comprehensive look at key components of running Pharmacogenomics (PGx) in your lab. The webinar will discuss the...
JUN 21, 2023 | 11:00 AM
A lot of exciting things are going on within the health care sector and AI [artificial intelligence] is playing a major role. AI is becoming increasingly popular in medicine and healthcare,...
Speaker:
Priv.-Doz. Dr. med. Ulrike Schumacher
, Dr. Steven Giglio
Sponsored By: Thermo Fisher Scientific
Real-time PCR, also known as quantitative PCR (qPCR), is the gold standard for sensitive, specific detection and quantification of nucleic acid targets. This qPCR technology as offered by Th...
MAY 31, 2023 | 10:00 AM
Date: May 31, 2023 Time: 10:00am (PDT), 1:00pm (EDT), 5:00pm (CEST) Bloodstream infections (BSIs) are defined as a systemic infection resulting from the presence of viable microorganisms in...
MAY 11, 2023 | 8:00 AM
Date: May 11, 2023 Time: 8:00am (PDT), 11:00am (EDT), 5:00pm (CEST) Quantitative genetic analysis plays a critical role in the research and development of novel biotherapeutics and vaccines....
-
MARCH 7, 2025Featuring emerging trends, new applications, and workflow solutions-Where Solutions Deliver Results!...JUN 08, 2023 | 12:30 AM PDTThe world's leading event for lab compliance solutions...JUN 22, 2022 | 3:00 AM PDTPlease join us for Ion World 2022, a virtual conference that will provide an opportunity to hear from scientists around the world, on how they are advancing research in a broad range of appl...JAN 25, 2022 | 1:00 AM PSTEurope - 10:00 AM Central European Time United Kingdom - 10:00 AM British Summer Time North America - 10:00 AM Central Standard Time Lab Compliance Connect – The world’s leading...DAY 1: OCTOBER 13/14, DAY 2: NOVEMBER 9/10Join us at IonWorld 2021, a virtual conference, where speakers will share their experiences in advancing clinical research using Ion Torrent™ Next-Generation Sequencing Solutions. Lear...
MARCH 7, 2025
Featuring emerging trends, new applications, and workflow solutions-Where Solutions Deliver Results!...
JUN 08, 2023
| 12:30 AM PDT
The world's leading event for lab compliance solutions...
JUN 22, 2022
| 3:00 AM PDT
Please join us for Ion World 2022, a virtual conference that will provide an opportunity to hear from scientists around the world, on how they are advancing research in a broad range of appl...
JAN 25, 2022
| 1:00 AM PST
Europe - 10:00 AM Central European Time United Kingdom - 10:00 AM British Summer Time North America - 10:00 AM Central Standard Time Lab Compliance Connect – The world’s leading...
DAY 1: OCTOBER 13/14, DAY 2: NOVEMBER 9/10
Join us at IonWorld 2021, a virtual conference, where speakers will share their experiences in advancing clinical research using Ion Torrent™ Next-Generation Sequencing Solutions. Lear...
SEP 08, 2021
| 6:00 AM PDT
Luminex's xMAP® Technology enables the evaluation of up to 500 analytes simultaneously in a single well, known as multiplexing. xMAP Technology uses color-coded microspheres as the substrate...
JUN 21, 2021
Ion chromatography (IC) is a critical analytical tool on which environmental, food safety, industrial, pharmaceutical, and biopharmaceutical labs rely to provide solutions to some of their m...
SEP 22, 2020
| 7:00 AM PDT
Agilent Technologies is pleased to bring you the Agilent Biopharma Workflow Solutions Virtual Symposium: Advances in Glycan and Sialic Acid Analysis...
SEP 08, 2020
| 5:30 AM PDT
Labroots is excited announce it's 6th Annual Event in the Microbiology Week Virtual Event Series!...